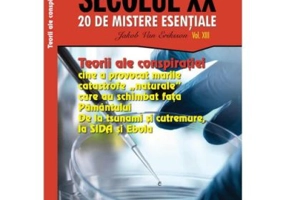
Teorii ale conspiratiei. Cine a provocat marile catastrofe „naturale” care au schimbat fata Pamantului - Jakob van Eriksson

Autor(i)
Jakob Van Eriksson
37 products available
Se afișează 1-25 din 37 produse

Președinții americani... Averile președinților americani
29 RON

Adevăruri teribile despre cele două Războaie Mondiale și cei care au stat în spatele lor (Vol. 1)
15.85 RON

Președinții americani... Miau-miau la Casa Albă!
29 RON

Președinții americani... Marile secrete ale președinților americani
24.53 RON30.66 RON

Președinții americani... Iubirile președinților americani
24.53 RON30.66 RON

CIA, KGB, Securitatea – legături secrete (Vol. 8)
14.99 RON

Președinții americani... Ciudățeniile președinților americani
29.9 RON

Președinții americani... Războaiele președinților americani
29 RON

Istorii interzise descoperite în arhivele secrete ale lumii (Vol. 9)
14.99 RON

Experimentul Philadelphia și alte programe militare secrete care demonstrează că viitorul a început ieri (Vol. 14)
15.06 RON15.85 RON

Teorii ale conspirației. Cine a provocat marile catastrofe „naturale” care au schimbat fața Pământului (Vol. 13)
15.06 RON15.85 RON

Al Treilea Război Mondial în formă continuată – Blestemul Apocalipsei moderne (Vol. 17)
15.06 RON15.85 RON

Președinții americani... Aventurile președinților americani
29 RON

Fight Club: Donald Trump vs. Joe Biden și Kamala Harris
52.75 Lei

Presedintii americani... Marile secrete ale presedintilor americani
29 RON

Averile presedintilor americani
30.66 RON

Presedintii americani... Pasiunile si hobby-urile presedintilor americani
30.66 RON

Adevaruri nespuse despre calatoriile spatiale si legaturile cu alte lumi - Jakob van Eriksson
11.09 RON15.85 RON

Istorii interzise descoperite in arhivele secrete ale lumii - Jakob van Eriksson
14.79 RON21.14 RON

Rufele pline de sange ale dictatorilor dintr-un secol violent - Jakob van Eriksson
11.09 RON15.85 RON

Adevaruri teribile despre cele doua Razboaie Mondiale si cei care au stat in spatele lor - Jakob van Eriksson
11.09 RON15.85 RON

Al Treilea Razboi Mondial in forma continuata – Blestemul Apocalipsei moderne - Jakob van Eriksson
11.09 RON15.85 RON

Experimentul Philadelphia si alte programe militare secrete care demonstreaza ca viitorul a inceput ieri - Jakob van Eriksson
14.79 RON21.14 RON

20 de atentate care au schimbat fata Secolului 20 - Jakob van Eriksson
11.09 RON15.85 RON
Teorii ale conspiratiei. Cine a provocat marile catastrofe „naturale” care au schimbat fata Pamantului - Jakob van Eriksson
11.09 RON15.85 RON